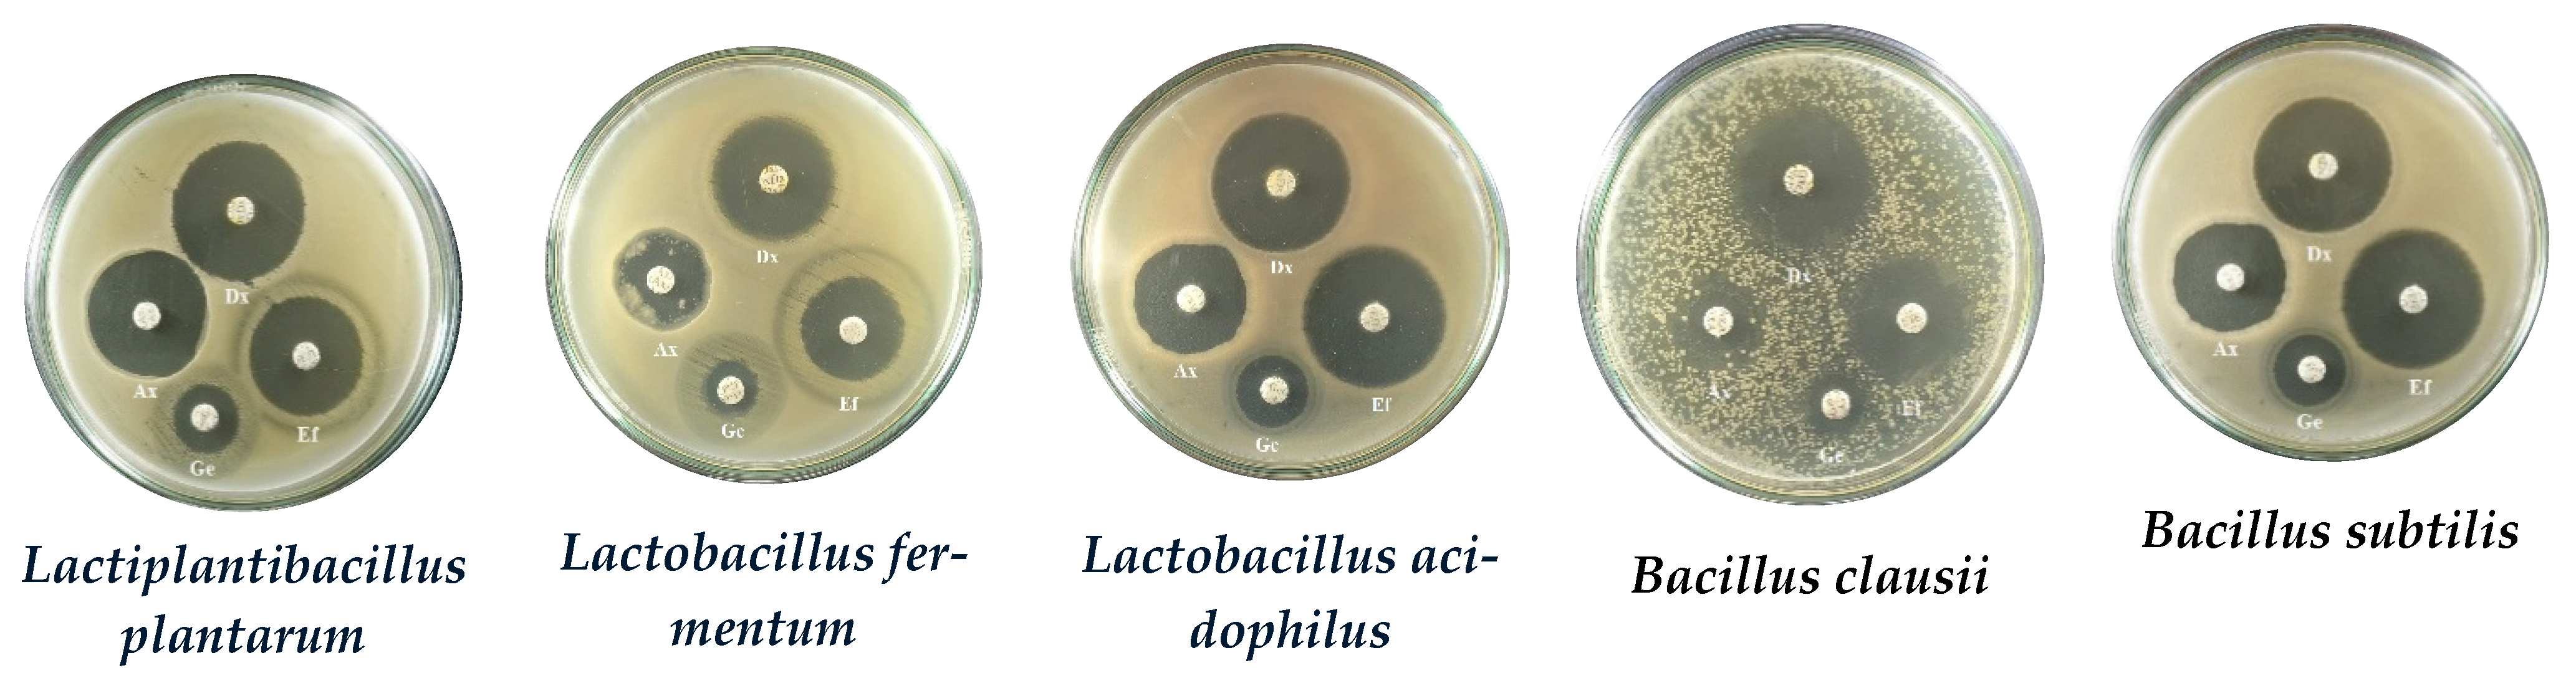
Foods 12 03810 g0a1
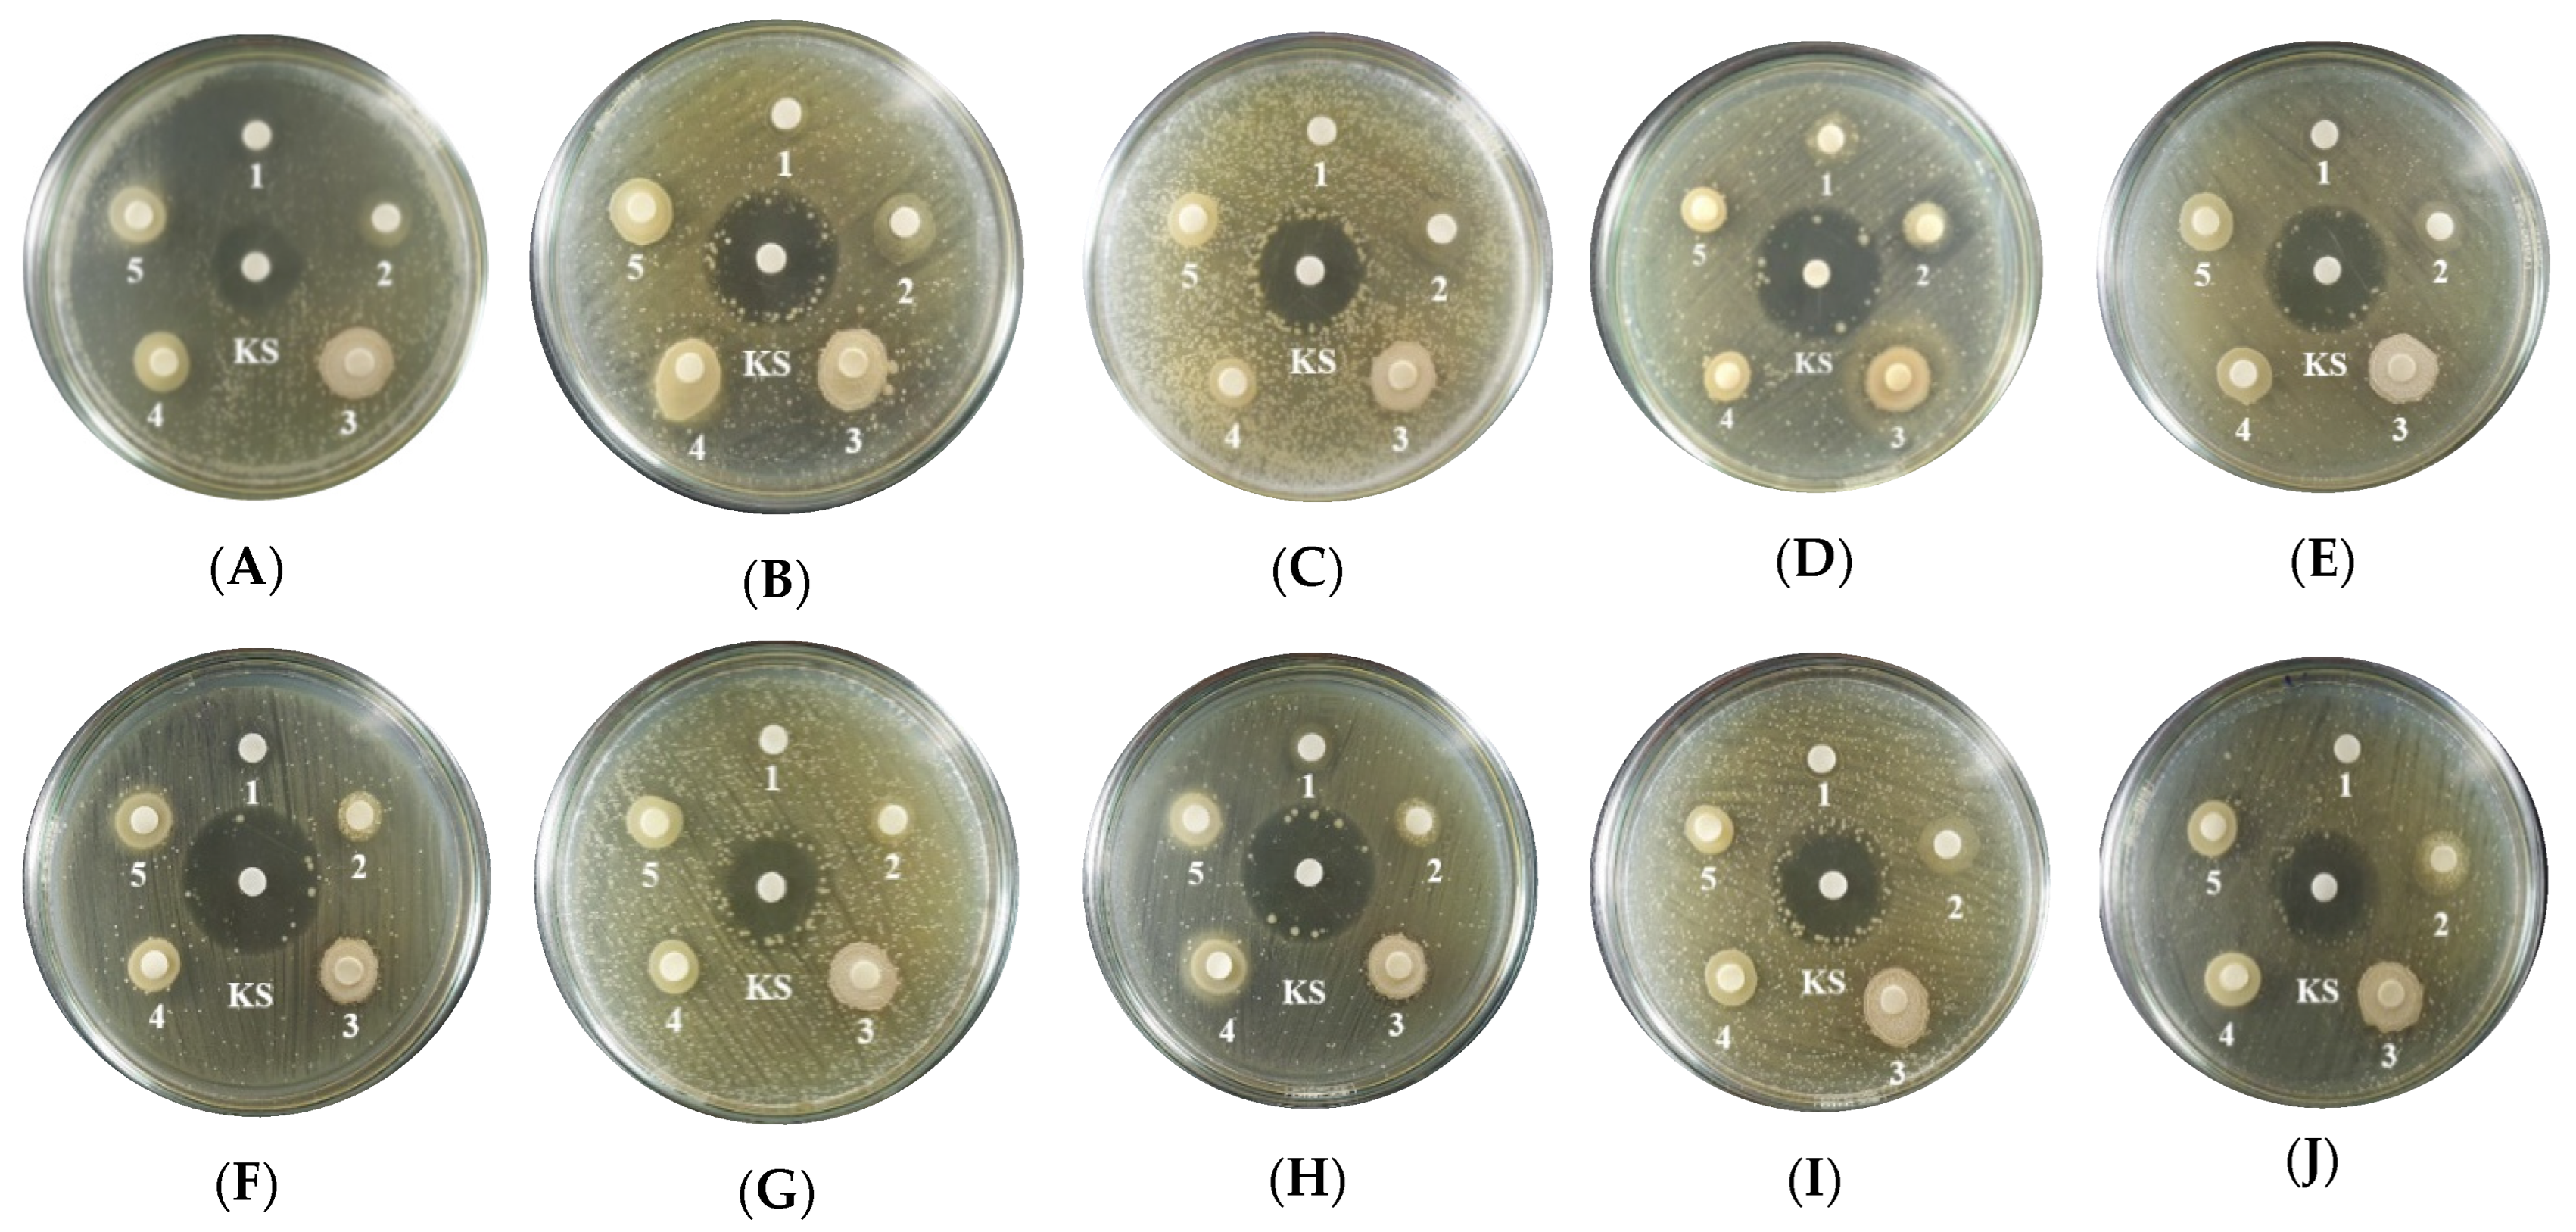
Foods 12 03810 g0a2
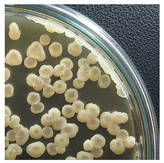
Foods 12 03810 i001
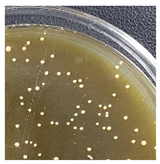
Foods 12 03810 i002
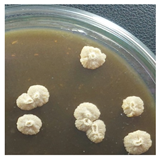
Foods 12 03810 i003
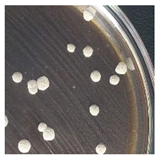
Foods 12 03810 i004
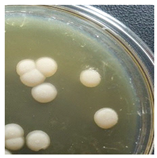
Foods 12 03810 i005
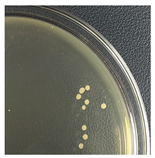
Foods 12 03810 i006

Isolation and Evaluation of the Probiotic Activity of Lactic Acid Bacteria Isolated from Pickled Brassica juncea (L.) Czern. et Coss.
Abstract
:1. Introduction
2. Materials and Methods
2.1. Materials and Chemicals
2.1.1. Material
2.1.2. Chemicals
2.2. Methods
2.2.1. Isolation, Morphological Characterization, Biochemical Testing, and Gene Sequencing of Probiotic Strains
2.2.2. Determination of Low pH Tolerance in Probiotic Strains
2.2.3. Determination of the Survival Ability in the Simulated Pepsin Media of Probiotic Strains
2.2.4. Determination of Viability in the Simulated Pancreatin Media of Probiotic Strains
2.2.5. Determination of the Ability to Survive in the Simulated Bile Salt Media of Probiotic Strains
2.2.6. Determination of the Hydrophobicity of Probiotic Strains
2.2.7. Determination of the Antibiotic Resistance of Probiotic Strains
2.2.8. Determination of the Resistance of Pathogenic Bacteria to Beneficial Bacteria
2.2.9. Statistical analysis
3. Results
3.1. Isolation of Probiotic Bacteria from Pickled Brassica juncea (L.) Czern. et Coss.
3.2. Viability of the Potential Probiotics Compared with Commercial Strains in Low pH Media
3.3. Survival Ability of the Potential Probiotics Compared with Commercial Strains in Pepsin-Containing Media
3.4. Viability of the Potential Probiotics Compared with Commercial Strains in Pancreatin Media
3.5. Ability of the Potential Probiotics Compared with Commercial Strains in Bile Salt Media
3.6. Investigation of the Hydrophobicity of Potential Probiotics Compared with Commercial Strains of Probiotics
3.7. Antibiotic Susceptibility of Isolated Compared to Commercial Strains of Probiotics
3.8. Evaluation of the Antibacterial Ability of Potential Probiotics Compared with Commercial Strains of Probiotics
4. Discussion
5. Conclusions
Author Contributions
Funding
Data Availability Statement
Acknowledgments
Conflicts of Interest
Appendix A. Gene Sequencing Results


Appendix B. Image Appendix

References
- Khalid, K. An Overview of Lactic Acid Bacteria. Int. J. Biosci. 2011, 1, 1–13. [Google Scholar]
 - George, F.; Daniel, C.; Thomas, M.; Singer, E.; Guilbaud, A.; Tessier, F.J.; Revol-Junelles, A.-M.; Borges, F.; Foligné, B. Occurrence and Dynamism of Lactic Acid Bacteria in Distinct Ecological Niches: A Multifaceted Functional Health Perspective. Front. Microbiol. 2018, 9, 2899. [Google Scholar] [CrossRef] [PubMed]
 - Peres, C.M.; Peres, C.; Hernández-Mendoza, A.; Malcata, F.X. Review on Fermented Plant Materials as Carriers and Sources of Potentially Probiotic Lactic Acid Bacteria–with an Emphasis on Table Olives. Trends Food Sci. Technol. 2012, 26, 31–42. [Google Scholar] [CrossRef]
 - Yu, A.O.; Leveau, J.H.J.; Marco, M.L. Abundance, Diversity and Plant-specific Adaptations of Plant-associated Lactic Acid Bacteria. Environ. Microbiol. Rep. 2020, 12, 16–29. [Google Scholar] [CrossRef]
 - Perez, R.H.; Zendo, T.; Sonomoto, K. Novel Bacteriocins from Lactic Acid Bacteria (LAB): Various Structures and Applications. Microb. Cell Fact. 2014, 13, S3. [Google Scholar] [CrossRef]
 - Ayivi, R.D.; Gyawali, R.; Krastanov, A.; Aljaloud, S.O.; Worku, M.; Tahergorabi, R.; da Silva, R.C.; Ibrahim, S.A. Lactic Acid Bacteria: Food Safety and Human Health Applications. Dairy 2020, 1, 202–232. [Google Scholar] [CrossRef]
 - Allen, A.P.; Dinan, T.G.; Clarke, G.; Cryan, J.F. A Psychology of the Human Brain–Gut–Microbiome Axis. Soc. Personal. Psychol. Compass 2017, 11, e12309. [Google Scholar] [CrossRef]
 - Umbrello, G.; Esposito, S. Microbiota and Neurologic Diseases: Potential Effects of Probiotics. J. Transl. Med. 2016, 14, 298. [Google Scholar] [CrossRef]
 - Messaoudi, M.; Lalonde, R.; Violle, N.; Javelot, H.; Desor, D.; Nejdi, A.; Bisson, J.-F.; Rougeot, C.; Pichelin, M.; Cazaubiel, M. Assessment of Psychotropic-like Properties of a Probiotic Formulation (Lactobacillus helveticus R0052 and Bifidobacterium longum R0175) in Rats and Human Subjects. Br. J. Nutr. 2011, 105, 755–764. [Google Scholar] [CrossRef]
 - Rao, A.V.; Bested, A.C.; Beaulne, T.M.; Katzman, M.A.; Iorio, C.; Berardi, J.M.; Logan, A.C. A Randomized, Double-Blind, Placebo-Controlled Pilot Study of a Probiotic in Emotional Symptoms of Chronic Fatigue Syndrome. Gut Pathog. 2009, 1, 6. [Google Scholar] [CrossRef]
 - El-Saadony, M.T.; Alagawany, M.; Patra, A.K.; Kar, I.; Tiwari, R.; Dawood, M.A.O.; Dhama, K.; Abdel-Latif, H.M.R. The Functionality of Probiotics in Aquaculture: An Overview. Fish Shellfish Immunol. 2021, 117, 36–52. [Google Scholar] [CrossRef] [PubMed]
 - Whorwell, P.J.; Altringer, L.; Morel, J.; Bond, Y.; Charbonneau, D.; O’mahony, L.; Kiely, B.; Shanahan, F.; Quigley, E.M.M. Efficacy of an Encapsulated Probiotic Bifidobacterium infantis 35624 in Women with Irritable Bowel Syndrome. Off. J. Am. Coll. Gastroenterol. ACG 2006, 101, 1581–1590. [Google Scholar] [CrossRef] [PubMed]
 - Moreira, M.T.C.; Martins, E.; Perrone, Í.T.; de Freitas, R.; Queiroz, L.S.; de Carvalho, A.F. Challenges Associated with Spray Drying of Lactic Acid Bacteria: Understanding Cell Viability Loss. Compr. Rev. Food Sci. Food Saf. 2021, 20, 3267–3283. [Google Scholar] [CrossRef] [PubMed]
 - Ganguly, N.K.; Bhattacharya, S.K.; Sesikeran, B.; Nair, G.B.; Ramakrishna, B.S.; Sachdev, H.P.S.; Batish, V.K.; Kanagasabapathy, A.S.; Muthuswamy, V.; Kathuria, S.C. ICMR-DBT Guidelines for Evaluation of Probiotics in Food. Indian J. Med. Res. 2011, 134, 22. [Google Scholar]
 - Liong, M.T.; Shah, N.P. Acid and Bile Tolerance and Cholesterol Removal Ability of Lactobacilli Strains. J. Dairy Sci. 2005, 88, 55–66. [Google Scholar] [CrossRef] [PubMed]
 - Charteris, K.; Morelli, C. Development and Application of an in Vitro Methodology to Determine the Transit Tolerance of Potentially Probiotic Lactobacillus and Bifidobacterium Species in the Upper Human Gastrointestinal Tract. J. Appl. Microbiol. 1998, 84, 759–768. [Google Scholar] [CrossRef] [PubMed]
 - Gilliland, S.E.; Nelson, C.R.; Maxwell, C. Assimilation of Cholesterol by Lactobacillus Acidophilus. Appl. Environ. Microbiol. 1985, 49, 377–381. [Google Scholar] [CrossRef]
 - Vinderola, C.G.; Medici, M.; Perdigon, G. Relationship between Interaction Sites in the Gut, Hydrophobicity, Mucosal Immunomodulating Capacities and Cell Wall Protein Profiles in Indigenous and Exogenous Bacteria. J. Appl. Microbiol. 2004, 96, 230–243. [Google Scholar] [CrossRef]
 - Hasali, N.O.R.H.; Zamri, A.I.; Lani, M.N.; Mubarak, A. Antibiotic Susceptibility, Antibacterial Activity and Probiotic Characterisation of Isolated Lactobacillus brevis Strains from Heterotrigona itama Honey. Malays. Appl. Biol. 2018, 47, 105–112. [Google Scholar]
 - Liu, S.; Zhang, Q.; Li, H.; Qiu, Z.; Yu, Y. Comparative Assessment of the Antibacterial Efficacies and Mechanisms of Different Tea Extracts. Foods 2022, 11, 620. [Google Scholar] [CrossRef]
 - Thankappan, B.; Ramesh, D.; Ramkumar, S.; Natarajaseenivasan, K.; Anbarasu, K. Characterization of Bacillus Spp. from the Gastrointestinal Tract of Labeo Rohita—Towards to Identify Novel Probiotics against Fish Pathogens. Appl. Biochem. Biotechnol. 2015, 175, 340–353. [Google Scholar] [CrossRef] [PubMed]
 - Lin, W.-H.; Hwang, C.-F.; Chen, L.-W.; Tsen, H.-Y. Viable Counts, Characteristic Evaluation for Commercial Lactic Acid Bacteria Products. Food Microbiol. 2006, 23, 74–81. [Google Scholar] [CrossRef] [PubMed]
 - Kaewnopparat, S.; Dangmanee, N.; Kaewnopparat, N.; Srichana, T.; Chulasiri, M.; Settharaksa, S. In Vitro Probiotic Properties of Lactobacillus Fermentum SK5 Isolated from Vagina of a Healthy Woman. Anaerobe 2013, 22, 6–13. [Google Scholar] [CrossRef] [PubMed]
 - Kang, C.-H.; Han, S.H.; Kim, Y.; Paek, N.-S.; So, J.-S. In Vitro Probiotic Properties of Lactobacillus Salivarius MG242 Isolated from Human Vagina. Probiotics Antimicrob. Proteins 2018, 10, 343–349. [Google Scholar] [CrossRef] [PubMed]
 - Ibrahim, A.; Fridayanti, A.; Delvia, F. Isolasi Dan Identifikasi Bakteri Asam Laktat (BAL) Dari Buah Mangga (Mangifera indica L.). J. Ilm. Manuntung 2015, 1, 159–163. [Google Scholar] [CrossRef]
 - Amelia, R.; Abdullah, D.; Pratama, Y.E.; Purwati, E. Antimicrobial Activity of Lactic Acid Bacteria Found in Dadiah on Disease-Causing Skin Infections. Indian J. Forensic Med. Toxicol. 2021, 15, 3314–3318. [Google Scholar]
 - Dung, N.T.P.; Ly, H.T.Y.; Phong, H.X. Phân Lập và Tuyển Chọn vi Khuẩn Lactic Có Khả Năng Sinh Chất Kháng Khuẩn. Tạp Chí Khoa Học Đại Học Cần Thơ 2011, 176–184. [Google Scholar]
 - Sakai, M.; Nagano, M.; Ohta, H.; Kida, K.; Morimura, S. Isolation of Lactic Acid Bacteria from Takanazuke as a Starter Strain to Reduce Added Salt and Stabilize Fermentation. Food Sci. Technol. Res. 2013, 19, 577–582. [Google Scholar] [CrossRef]
 - Baloch, M.N.; Siddiqui, R.; Asad, W.; Saeed, A.; Haider, F. Probiotic Potential of Novel Strains of Lactobacillus plantarum Lp-1: In Vitro Studies. Pak. J. Pharm. Sci. 2019, 32, 445–452. [Google Scholar]
 - Khalil, E.S.; Abd Manap, M.Y.; Mustafa, S.; Alhelli, A.M.; Shokryazdan, P. Probiotic Properties of Exopolysaccharide-Producing Lactobacillus Strains Isolated from Tempoyak. Molecules 2018, 23, 398. [Google Scholar] [CrossRef]
 - Sahadeva, R.P.K.; Leong, S.F.; Chua, K.H.; Tan, C.H.; Chan, H.Y.; Tong, E.V.; Wong, S.Y.W.; Chan, H.K. Survival of Commercial Probiotic Strains to PH and Bile. Int. Food Res. J. 2011, 18, 1515–1522. [Google Scholar]
 - Sidira, M.; Galanis, A.; Ypsilantis, P.; Karapetsas, A.; Progaki, Z.; Simopoulos, C.; Kourkoutas, Y. Effect of Probiotic-Fermented Milk Administration Ongastrointestinal Survival of Lactobacillus Casei ATCC 393 and Modulation of Intestinal Microbial Flora. Microb. Physiol. 2011, 19, 224–230. [Google Scholar] [CrossRef] [PubMed]
 - Masco, L.; Crockaert, C.; Van Hoorde, K.; Swings, J.; Huys, G. In Vitro Assessment of the Gastrointestinal Transit Tolerance of Taxonomic Reference Strains from Human Origin and Probiotic Product Isolates of Bifidobacterium. J. Dairy Sci. 2007, 90, 3572–3578. [Google Scholar] [CrossRef] [PubMed]
 - Shokryazdan, P.; Sieo, C.C.; Kalavathy, R.; Liang, J.B.; Alitheen, N.B.; Faseleh Jahromi, M.; Ho, Y.W. Probiotic Potential of Lactobacillus Strains with Antimicrobial Activity against Some Human Pathogenic Strains. Biomed. Res. Int. 2014, 2014, 927268. [Google Scholar] [CrossRef] [PubMed]
 - Zhang, X.; Esmail, G.A.; Alzeer, A.F.; Arasu, M.V.; Vijayaraghavan, P.; Choi, K.C.; Al-Dhabi, N.A. Probiotic Characteristics of Lactobacillus Strains Isolated from Cheese and Their Antibacterial Properties against Gastrointestinal Tract Pathogens. Saudi J. Biol. Sci. 2020, 27, 3505–3513. [Google Scholar] [CrossRef]
 - Urdaneta, V.; Casadesús, J. Interactions between Bacteria and Bile Salts in the Gastrointestinal and Hepatobiliary Tracts. Front. Med. 2017, 4, 163. [Google Scholar] [CrossRef]
 - Tuo, Y.; Yu, H.; Ai, L.; Wu, Z.; Guo, B.; Chen, W. Aggregation and Adhesion Properties of 22 Lactobacillus Strains. J. Dairy Sci. 2013, 96, 4252–4257. [Google Scholar] [CrossRef]
 - Dhewa, T.; Pant, S.; Goyal, N.; Mishra, V. Adhesive Properties of Food and Faecal Potential Probiotic Lactobacilli. J. Appl. Nat. Sci. 2009, 1, 138–140. [Google Scholar] [CrossRef]
 - Li, T.; Teng, D.; Mao, R.; Hao, Y.; Wang, X.; Wang, J. A Critical Review of Antibiotic Resistance in Probiotic Bacteria. Food Res. Int. 2020, 136, 109571. [Google Scholar] [CrossRef]
 - Lê Thị Hải Yến, N.Đ. Khảo Sát Đặc Tính Probiotic Các Chủng vi Khuẩn Bacillus Subtilis Phân Lập Tại Các Tỉnh Đồng Bằng Sông Cửu Long. Tạp Chí Khoa Học Trường Đại Học Cần Thơ 2016, 26–32. [Google Scholar]
 - Tharmaraj, N.; Shah, N.P. Antimicrobial Effects of Probiotics against Selected Pathogenic and Spoilage Bacteria in Cheese-Based Dips. Int. Food Res. J. 2009, 16, 261–276. [Google Scholar]
 - Coman, M.M.; Verdenelli, M.C.; Cecchini, C.; Silvi, S.; Orpianesi, C.; Boyko, N.; Cresci, A. In Vitro Evaluation of Antimicrobial Activity of Lactobacillus rhamnosus IMC 501®, Lactobacillus paracasei IMC 502® and SYNBIO® against Pathogens. J. Appl. Microbiol. 2014, 117, 518–527. [Google Scholar] [CrossRef] [PubMed]
 - Tegegne, B.A.; Kebede, B. Probiotics, Their Prophylactic and Therapeutic Applications in Human Health Development: A Review of the Literature. Heliyon 2022, 8, e09725. [Google Scholar] [CrossRef] [PubMed]
 
| Source | Numbers of Bacterial Strains | Symbol | 
|---|---|---|
| Go Vap Coopmart Supermarket | 6 | A1, A2, A3, A4, A5, A6 | 
| Go Vap Market | 5 | B1, B2, B3, B4, B5 | 
| Thu Duc Market | 5 | C1, C2, C3, C4, C5 | 
| Go Vap Emart Supermarket | 6 | D1, D2, D3, D4, D5, D6 | 
| Initial Colony Strains | Colony Strains with Similar Morphological Characteristics | Morphological Characteristics | Illustrating Images | 
|---|---|---|---|
| A1, B2, C1, D4 | N1 | Colonies are pale yellow, relatively round, quite large, prominent on the surface of the agar plate, the surface is a membrane covering the inner liquid, the surface is not glossy, slightly wrinkled, and the cover is tooth-shaped light saw. | ![]()  | 
| A5, B3, C2, B5 | N2 | Colonies are ivory-white, relatively round, small, floating on the surface of the agar plate, the surface and inside of the colonies are uniform, glossy surfaces, round covers. | ![]()  | 
| A2, B1, C4, D2 | N3 | Colonies are ivory white, rough surface, irregular round shapes, surface with raised small circles, uniform surface and inside, slightly serrated covers. | ![]()  | 
| A3, C3, D3, B4 | N4 | Colonies are milky white, rough surface, slightly rounded shapes protruding above the surface of the plate, the surface and inside of the colony are uniform, round cover. | ![]()  | 
| A4, C5, D5 | N5 | Colonies are ivory white, spherical, prominent on the surface of the agar plate, smooth surface, not glossy, uniform surface and inside, round cover. | ![]()  | 
| C6, D1, A6 | N6 | Colonies are ivory white, almost round, slightly raised on the agar surface, glossy and plump surface, and round cover. | ![]()  | 
| Colony Group | Morphological Characteristics | Image under a 100× Microscope | 
|---|---|---|
| N1 | Short rod-shaped, Gram-positive bacteria | ![]()  | 
| N2 | Long rod-shaped, Gram-positive bacteria | ![]()  | 
| N3 | Short rod-shaped, Gram-positive bacteria | ![]()  | 
| N4 | Short rod-shaped, Gram-positive bacteria | ![]()  | 
| N5 | Short rod-shaped, Gram-negative bacteria | ![]()  | 
| N6 | Short rod-shaped, Gram-positive bacteria | ![]()  | 
| Bacterial Strains | Catalase Test | Color Change of Glucose Solution (after 24 h Incubation with Bacteria and Bromocresol Green Reagent) | pH of Glucose Solution (after 24 h Incubation with Bacteria) | 
|---|---|---|---|
| N1 | ![]() (+)  | ![]()  | 5.43 | 
| N2 | ![]() (-)  | ![]()  | 3.45 | 
| N3 | ![]() (-)  | ![]()  | 6.15 | 
| N4 | ![]() (+)  | ![]()  | 5.82 | 
| N5 | ![]() (+)  | ![]()  | 5.65 | 
| N6 | ![]() (+)  | ![]()  | 2.76 | 
| Accession | Description | Query Coverage (%) | E-Value | Max Identity (%) | 
|---|---|---|---|---|
| MT611892.1 | Lactobacillus fermentum strain 2953 16S ribosomal RNA gene, partial sequence | 100 | 0.0 | 100 | 
| OQ891485.1 | Lactiplamtibacillus plantarum strain KUMS-C47 16S ribosomal RNA gene, partial sequence | 100 | 0.0 | 100 | 
| pH 1 | pH 2 | pH 3 | |||||||
|---|---|---|---|---|---|---|---|---|---|
| 30 min | 90 min | 180 min | 30 min | 90 min | 180 min | 30 min | 90 min | 180 min | |
| L. acidophilus | 51.57 ± 2.39 bD | 1.62 ± 0.01 cA | 0 ± 0 aA | 70.43 ± 3.61 bcE | 53.98 ± 0.86 cD | 24.51 ± 0.18 dB | 86.41 ± 0.12 dG | 77.43 ± 0.17 eF | 35.45 ± 0.06 dC | 
| B. subtilis | 46.38 ± 1.52 bE | 4.04 ± 0.11 eB | 0 ± 0 aA | 76.37 ± 3.15 cH | 56.97 ± 0.38 dF | 28.35 ± 0.14 eC | 87.18 ± 0.10 eI | 65.29 ± 0.12 bG | 34.26 ± 0.23 cD | 
| B. clausii | 30.46 ± 0.95 aC | 1.30 ± 0.07 bA | 0 ± 0 aA | 68.90 ± 1.60 bF | 50.93 ± 0.46 bE | 21.13 ± 0.07 bB | 80.18 ± 0.24 bG | 68.24 ± 0.19 dF | 37.54 ± 0.26 eD | 
| L. fermentum | 28.25 ± 0.53 aE | 0.93 ± 0.01 aB | 0 ± 0 aA | 58.25 ± 0.22 aH | 43.9 ± 0.41 aF | 18.41 ± 0.09 aC | 67.17 ± 0.06 aI | 49.32 ± 0.08 aG | 27.41 ± 0.04 aD | 
| L. plantarum | 34.52 ± 5.78 aC | 2.53 ± 0.14 dA | 0 ± 0 aA | 72.54 ± 0.45 bcE | 52.28 ± 1.18 bcD | 22.67 ± 0.40 cB | 83.11 ± 0.09 cF | 67.38 ± 0.06 cE | 33.42 ± 0.09 bC | 
| Percentage Survival Rate of Bacteria in Pepsin Media (%) | |||
|---|---|---|---|
| 30 min | 90 min | 180 min | |
| L. acidophilus | 61.33 ± 0.25 dC | 55.02 ± 0.00 eA | 47.45 ± 0.22 dB | 
| B. subtilis | 52.12 ± 0.08 cC | 47.06 ± 0.04 cA | 43.19 ± 0.05 eB | 
| B. clausii | 46.01 ± 0.01 bC | 37.08 ± 0.01 bA | 31.22 ± 0.04 bB | 
| L. fermentum | 42.11 ± 0.09 aC | 25.04 ± 0.04 aA | 18.20 ± 0.06 aB | 
| L. plantarum | 65.08 ± 0.10 eC | 49.04 ± 0.01 dA | 41.16 ± 0.14 cB | 
| Percentage Survival Rate of Bacteria in Pancreatin Media (%) | ||||
|---|---|---|---|---|
| 1 h | 2 h | 3 h | 4 h | |
| L. acidophilus | 96.35 ± 0.02 cC | 96.25 ± 0.00 cC | 95.27 ± 0.15 bB | 94.27 ± 0.07 bA | 
| B. subtilis | 98.15 ± 0.04 eB | 98.57 ± 0.00 eC | 97.13 ± 0.11 dA | 97.13 ± 0.78 dA | 
| B. clausii | 94.86 ± 0.01 aC | 94.18 ± 0.16 aB | 94.27 ± 0.04 aB | 93.15 ± 0.04 aA | 
| L. fermentum | 95.19 ± 0.01 bB | 95.12 ± 0.08 bB | 95.2 ± 0.10 bB | 94.36 ± 0.05 bA | 
| L. plantarum | 97.25 ± 0.02 dB | 97.24 ± 0.03 dB | 96.2 ± 0.12 cA | 96.2 ± 0.12 cA | 
| Percentage Survival Rate of Bacteria in Bile Salt Media (%) | ||||
|---|---|---|---|---|
| 1 h | 2 h | 3 h | 4 h | |
| L. acidophilus | 81.2 ± 0.04 cD | 73.42 ± 0.13 cC | 67.09 ± 0.08 cB | 56.2 ± 0.07 cA | 
| B. subtilis | 92.19 ± 0.05 eD | 86.15 ± 0.03 eC | 75.19 ± 0.08 eB | 64.17 ± 0.05 eA | 
| B. clausii | 78.12 ± 0.13 bD | 66.26 ± 0.09 bC | 57.24 ± 0.19 bB | 44.15 ± 0.07 bA | 
| L. fermentum | 65.07 ± 0.04 aD | 52.13 ± 0.07 aC | 48.14 ± 0.08 dB | 39.27 ± 0.05 aA | 
| L. plantarum | 89.42 ± 0.22 dD | 82.16 ± 0.07 dC | 76.11 ± 0.02 aB | 62.3 ± 0.06 dA | 
| Bacteria | Percentage Average Hydrophobicity (%) | 
|---|---|
| B. subtilis | 40.42 ± 0.74 e | 
| L. plantarum | 30.95 ± 0.91 d | 
| B. clausii | 26.03 ± 0.31 c | 
| L. acidophilus | 22.45 ± 1.27 b | 
| L. fermentum | 18.67 ± 0.84 a | 
| Bacteria | Inhibition Ring Diameter (mm) | |||
|---|---|---|---|---|
| Type of Antibiotic | ||||
| Doxycycline 30 μg | Enrofloxacin 5 μg | Gentamicin 10 μg | Amoxicillin 10 μg | |
| B. subtilis | 29.67 ± 0.58 a | 25.00 ± 1.00 ab | 12.33 ± 0.58 a | 28.67 ± 0.58 b | 
| L. plantarum | 30.33 ± 1.53 a | 23.00 ± 1.00 a | 13.33 ± 0.58 ab | 27.33 ± 1.59 b | 
| B. clausii | 30.33 ± 1.53 a | 30.67 ± 1.53 c | 15.67 ± 1.53 b | 22.67 ± 1.16 a | 
| L. acidophilus | 29.67 ± 1.53 a | 24.67 ± 1.52 ab | 14,67 ± 0.58 ab | 26.00 ± 1.00 ab | 
| L. fermentum | 30.67 ± 1.55 a | 26.67 ± 1.15 b | 13.67 ± 1.16 ab | 27.00 ± 1.73 b | 
| Bacteria | Inhibition Zone Diameter (mm) | |||||
|---|---|---|---|---|---|---|
| L. acidophilus | B. clausii | B. subtilis | L. fermentum | L. plantarum | Ciprofloxacin | |
| B. cereus | 11.00 ± 1.00 a | 12.33 ± 0.57 ab | 14.66 ± 0.57 b | 12.66 ± 0.57 ab | 12.33 ± 0.57 ab | 24.00 ± 1.73 c | 
| C. jejuni | 9.66 ± 1.15 a | 13.33 ± 1.15 bc | 15.00 ± 0.00 c | 12.00 ± 1.00 ab | 14.00 ± 0.00 bc | 27.33 ± 1.52 c | 
| C. freundii | 9.33 ± 1.15 a | 12.00 ± 1.00 ab | 13.33 ± 0.57 b | 11.66 ± 0.57 ab | 12.00 ± 1.00 ab | 23.00 ± 1.73 c | 
| E. coli | 10.66 ± 0.57 a | 11.66 ± 0.57 a | 15.66 ± 0.57 b | 12.00 ± 1.00 ab | 11.33 ± 1.52 a | 30.00 ± 0.00 c | 
| L. monocytogenes | 9.00 ± 1.00 a | 11.66 ± 0.57 b | 14.66 ± 0.57 c | 12.00 ± 0.00 b | 12.33 ± 0.57 b | 23.00 ± 1.73 c | 
| P. mirabilis | 7.00 ± 0.00 a | 9.00 ± 1.00 b | 13.66 ± 1.15 d | 11.33 ± 0.57 c | 11.66 ± 0.57 c | 28.33 ± 1.52 e | 
| S. boydii | 7.66 ± 0.57 a | 11.66 ± 0.57 b | 15.00 ± 1.00 c | 11.00 ± 1.00 b | 12.66 ± 1.52 bc | 26.00 ± 1.73 d | 
| S. typhimurium | 10.00 ± 0.00 a | 11.00 ± 1.00 ab | 13.66 ± 0.57 c | 12.00 ± 1.00 b | 12.33 ± 0.57 bc | 30.00 ± 0.00 d | 
| S. aureus | 9.33 ± 0.57 a | 12.00 ± 0.00 a | 13.66 ± 0.57 a | 12.66 ± 1.15 a | 12.33 ± 1.52 a | 23.00 ± 3.46 b | 
| V. parahaemolyticus | 9.33 ± 0.57 a | 12.00 ± 1.00 b | 14.33 ± 0.57 c | 13.33 ± 0.57 bc | 12.00 ± 1.00 b | 21.00 ± 0.00 d | 
Disclaimer/Publisher’s Note: The statements, opinions and data contained in all publications are solely those of the individual author(s) and contributor(s) and not of MDPI and/or the editor(s). MDPI and/or the editor(s) disclaim responsibility for any injury to people or property resulting from any ideas, methods, instructions or products referred to in the content.  | 
© 2023 by the authors. Licensee MDPI, Basel, Switzerland. This article is an open access article distributed under the terms and conditions of the Creative Commons Attribution (CC BY) license (https://creativecommons.org/licenses/by/4.0/).
Share and Cite
Nguyen, N.H.K.; Giang, B.L.; Truc, T.T. Isolation and Evaluation of the Probiotic Activity of Lactic Acid Bacteria Isolated from Pickled Brassica juncea (L.) Czern. et Coss. Foods 2023, 12, 3810. https://doi.org/10.3390/foods12203810
Nguyen NHK, Giang BL, Truc TT. Isolation and Evaluation of the Probiotic Activity of Lactic Acid Bacteria Isolated from Pickled Brassica juncea (L.) Czern. et Coss. Foods. 2023; 12(20):3810. https://doi.org/10.3390/foods12203810
Chicago/Turabian StyleNguyen, Nguyen Hong Khoi, Bach Long Giang, and Tran Thanh Truc. 2023. "Isolation and Evaluation of the Probiotic Activity of Lactic Acid Bacteria Isolated from Pickled Brassica juncea (L.) Czern. et Coss." Foods 12, no. 20: 3810. https://doi.org/10.3390/foods12203810
APA StyleNguyen, N. H. K., Giang, B. L., & Truc, T. T. (2023). Isolation and Evaluation of the Probiotic Activity of Lactic Acid Bacteria Isolated from Pickled Brassica juncea (L.) Czern. et Coss. Foods, 12(20), 3810. https://doi.org/10.3390/foods12203810